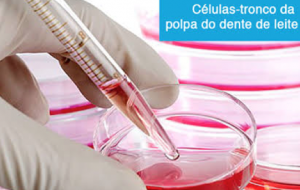

| TECNOLOGIA APLICADA: | DESCRIÇÃO: |
|
|
Microscópio A microscopia operatória atua em todas as áreas da Odontologia, maximizando as imagens com alta tecnologia. O uso do microscópio proporciona uma Odontologia minimamente invasiva. |
 |
Ultrassom em Endodontia Na Endodontia auxilia na irrigação dos canais radiculares, remoção de medicações, instrumentos fraturados, pinos intra radiculares e na procura de canais atresicos ou calcificados. |
|
|
Aparelho Rotatório e Reciprocante em Endodontia Com um único aparelho conseguimos adequada limpeza, modelagem dos canais, boa qualidade, menor tempo e maior sucesso. |
 |
Morpheus – Anestesia Computadorizada Morpheus anestesia computadorizada, com mais conforto e segurança para o paciente. |
|
|
MEDO DE INJEÇÃO NO DENTISTA! Nós temos anestesia SEM AGULHA. Aicmofobia ou Aiquimofobia é uma fobia muito real que afeta 3,5% a 10% da população do mundo, consiste de um medo irracional ou excessivo de agulhas, alfinetes ou injeções. A tecnologia da anestesia sem agulha, oferece biossegurança, conforto, eficiência na maioria dos procedimentos odontológicos, intra e extra orais. |
|
|
Sensor Digital Radiografias Intraoral Realiza radiografias em tempo real, com a mínima incidência de radiação para o profissional e paciente (50% menos radiação), máxima qualidade de imagem de diagnóstico, ecologicamente indicado. |
|
|
Check Up Digital Preventivo Imagens intra bucais realizados com precisão (60x do tamanho normal). O diagnóstico é realizado após análise das imagens em alta resolução, problemas iniciais são detectados e os procedimentos indicados. Acompanhamento individualizado de sua condição bucal. |
|
|
Aparelho Laser – Cirúrgico Plástica gengival (correção do contorno gengival harmonizando o sorriso). Procedimentos cirúrgicos precisos intra oral e extra oral. Aplicações nas doenças periodontais e tratamentos de canal (descontaminação de micro-organismos). Procedimentos pouco invasivos. |

|
Papacárie É um gel, que quando aplicado na cárie, ela amolece e conseguimos removê-la sem utilizar o “motorzinho”. A remoção é feita com instrumentos cortantes que raspamo tecido cariado, tendo um maior controle e certeza do que estamos removendo. |
|
|
Coleta de células tronco da polpa do dente de leite É um procedimento não invasivo que é feito durante o período das trocas de dentes da criança. Essas células são jovens e em grandes quantidades e excelente qualidade. Essas células podem ser congeladas feito durante o período das trocas de dentes da criança. Essas células podem ser congeladas e utilizadas em tratamentos futuros de doenças degenerativas. |
|
|
Aparelho Graduador de Halitose O aparelho mede a concentração de gases responsáveis pelo mau hálito. Auxiliando no diagnóstico, tratamento e prevenção da halitose, os gases são produzidos na boca pela placa bacteriana, saburra lingual e casos de infecção nas amígdalas. |
  |
Clareamento a Laser Clareamento dentário realizado com segurança, rapidez e alta qualidade. Efeito máximo na estética do sorriso, controle da sensibilidade dos dentes durante e após clareamento. Rejuvenescimento do sorriso. |
A presibilidade nos tratamentos estéticos através de Enceramento e Mock Up
O termo mock-up é uma adaptação do inglês para nossa língua, é utilizado para denominar um esboço, uma réplica, uma maquete, um ensaio de teste para visualizar o resultado do que se espera.
Em odontologia este ensaio pode ser muito importante em alguns casos. Quando fazemos um modelo de estudo da boca a ser transformada, perdemos algumas referencias como linha média e linha interpupilar sem elas podemos cometer alguns erros como inclinar a linha média durante o enceramento diagnóstico, desalinhando todo o sorriso.
O enceramento diagnóstico será transferido através de um guia para a boca, então o estudo deve estar muito próximo da perfeição em simetria e alinhamento.
Mock up em resina Acrílica caracterizado, sendo removido do modelo de gesso para instalação em boca, observe que todos os dentes estão unidos para promover um posicionamento mais próximo possível do enceramento diagnóstico.
O mock-up pode ser realizado previamente em modelo de gesso em resina acrílica e encaixado nos dentes para visualizar o estudo, no entanto este procedimento também pode ser feito diretamente na boca com as mesmas resinas que irão ser utilizadas (fazendo também uma prova de cor) ou com uma resina chamada de bis-acril em uma só cor, como na segunda foto acima.
Quando há uma assimetria muito grande de bordas incisais, gengiva e lábios como no caso ilustrado o mock up se torna indispensável. Com o mock-up posicionado podemos verificar que o o lado esquerdo do paciente está comas bordas mais baixas que o direito e não segue a curvatura do lábio inferior. Sabendo disso devo transferir esta informação para o meu enceramento para que eu tenha uma maior previsibilidade ao confeccionar as lentes de contato para este paciente.
Sistema CAD CAM na odontologia e Impressoras 3D
A técnica consiste na utilização de computador na fabricação de coroas de cerâmica individualizada para a sua boca. Este processo é possível com a captação da imagem do seu dente com uma câmara especial. Esta imagem pode ser captada diretamente na boca ou através do scaneamento de uma moldagem. A precisão de ajustes destas coroas é muito alta, com uma margem de erro mínima.
PROCESSO
Inicialmente o dente em questão é preparado pelo dentista.
Após o preparo, é captado uma imagem dos seus dentes com uma câmara intraoral, através de um scanner, sendo este um processo confortável e totalmente indolor.
Em casos de nao haver o scanner em consultório, o dentista poderá realizar uma moldagem e este scaneamento ser realizado no molde.Esta imagem captada é transformada em um modelo virtual 3D da sua boca, sobre a qual se desenha uma coroa perfeitamente adaptada à sua boca e ao preparo que foi realizado. Em seguida, conecta-se o computador a uma unidade fresadora que irá cortar, a partir de um bloco de cerâmica na cor e material selecionado em uma coroa em cerâmica pura.
Após a fresagem a coroa está pronta para prova, ajustes e cimentação em boca.
Com esta tecnologia conseguimos efetuar um tratamento mais rápido, com mínimos ajustes e material de alta estética e funcionalidade.
Coroas E-max são coroas (revestem os dentes), livres de metal e portanto, transmitem uma maior naturalidade aos dentes de porcelana. O material é desenvolvido na Ivoclar Vivadent, empresa Suíça, e atua com uma tecnologia de adaptação e conformação estética incríveis.
Cerâmicas altamente estéticas e resistentes – E-MAX
As Coroas E-max são feitas com o melhor material disponível no mercado, o que a torna a melhor opção estética disponível hoje, tanto para dentes posteriores (do fundo), quanto para os anteriores (da frente). São livres de metal e portanto, não possuem uma borda escura, muito comum em coroas com metal. A ausência de metal também possibilita uma correta passagem da luz pelo dente, mimetizando a beleza apenas encontradas em dentes naturais perfeitos.
Coroas de E-max são puras obras de arte, e são utilizadas tanto para reconstrução de apenas um dente quanto para montagem de sorrisos inteiramente novos. Hoje, com a crescente demanda estética, o sorriso perfeito se tornou possível e mais acessível, com o uso deste material. Juntamente com tecnologia de computação gráfica para desenho dos dentes, e impressoras 3D, estes trabalhos estão sendo fabricados com precisão milimétrica, polimento perfeito, cor ideal, estética impecável e tempo/custo reduzidos.